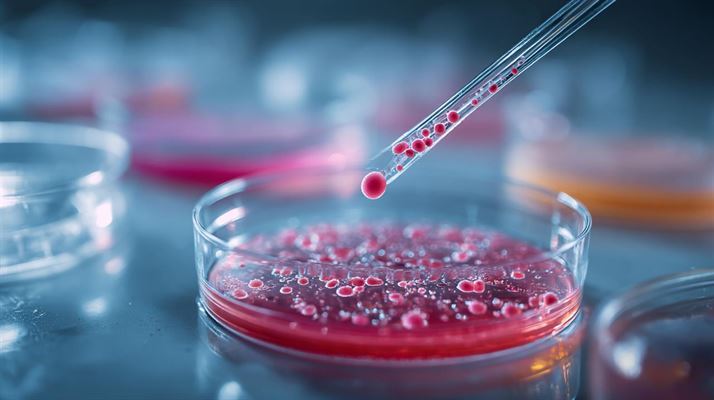
Petriskål - et uundværligt værktøj i laboratoriet

Diverse

Kvalitets havemøbler - en guide til dit udendørs paradis
Er du på udkig efter havemøbler, der både er stilfulde, komfortable og holdbare? I så fald er kvalitets havemøbler det rette valg for dig. I denne artikel vil vi dække alt, hvad du behøver at vide for

Hjælp til computer privat - få styr på din teknologi derhjemme
I dagens digitale tidsalder er computere blevet en uundværlig del af vores dagligdag. Uanset om du bruger din computer til arbejde, skole eller fritid, kan tekniske problemer opstå og kræve hjælp. Den

Kørekort aalborg - en omfattende guide
At tage kørekort er en betydningsfuld milepæl i mange menneskers liv. Uanset om du er ung og tager dit første kørekort, eller du er ældre og ønsker at få det kørekort, du aldrig har taget, er det en v

Bloomingville - en verden af stil og æstetik
Drømmer du om et hjem fyldt med nordisk charme og elegance? Så er Bloomingville muligvis det brand, du har ventet på. Med et bredt sortiment af boliginteriør og dekorationer, har Bloomingville noget f

Køkkenredskaber - en uundværlig del af dit køkken
Når det kommer til at tilberede fantastiske måltider, er de rette køkkenredskaber afgørende. Uanset om du er en professionel kok eller en hjemme-entusiast, gør kvalitetsredskaber processen både

Ametyst sten - betydning, egenskaber og brug
Ametyst sten er kendt for deres skønhed og spirituelle egenskaber. I denne artikel vil vi udforske alt, hvad du behøver at vide om ametyst sten, fra deres oprindelse og betydning til hvordan du kan in

Frokostordning herning - en smagfuld løsning for virksomheder
I en travl arbejdsdag er frokosten et vigtigt element, der påvirker medarbejdernes energi og produktivitet. En Køb Frokostordning herning her tilbyder en praktisk og velsmagende løsning for virk

Find billigt internet på din adresse
Internet er blevet en uundværlig del af vores hverdag, men det behøver ikke koste en formue. Hvis du leder efter måder at find billigt internet på din adresse , er du kommet til det rette sted. I

Barberstole - komfort og stil til frisører
Barberstole er en essentiel del af enhver frisørsalon, og de tjener både som et funktionelt og æstetisk element i indretningen. I denne artikel vil vi dykke ned i, hvad der gør barberstole så vigtige,
Petriskål - et uundværligt værktøj i laboratoriet
I laboratoriet er en petriskål et af de mest fundamentale og uundværlige redskaber for forskere og laboratoriemedarbejdere. Men hvad er præcis en petriskål, og hvordan anvendes den i laboratorieforskn

Puslespil til 4-årige - en verden af læring og sjov
I den tidlige barndom er leg en vigtig del af udviklingen. For børn på omkring 4 år er puslespil en fantastisk måde at styrke både kognitive og motoriske evner på. I denne artikel udforsker vi, hvorda

Miele ovn - din guide til perfekt madlavning
Ønsker du en ovn, der kan tage din madlavning til det næste niveau? Med en miele ovn får du en kombination af høj kvalitet, innovativ teknologi og stilfuldt design. I denne artikel vil vi udfors

Kummefryser tilbud - find den bedste pris online
Er du på udkig efter en ny kummefryser, men vil gerne sikre dig at få mest muligt ud af dine penge? Så er du kommet til det rette sted. I denne artikel vil vi guide dig gennem de vigtigste aspekter ve

Sushi buffet - en oplevelse af smag og variation
Er du en sushi-elsker? Så er en sushi buffet den perfekte måde at opleve en verden af smag og variation på. En sushi buffet tilbyder et bredt udvalg af forskellige sushityper, der tilfredsstiller selv

Bredt udvalg af lækre is-varianter
Når solen skinner, og temperaturen stiger, er der intet så forfriskende som en lækker is. Uanset om du er til flødeis, sorbet eller noget helt andet, findes der en verden af lækre is-varianter, der ka

Hillesvåg garn - kvalitet og tradition fra norge
I en verden, hvor kvalitet og tradition har en stigende betydning, står Hillesvåg garn ud som en pålidelig leverandør af førsteklasses strikkegarn. Hvis du ønsker at udforske den fantastiske verden af

Professionel rengøring i Odense - en guide til skinnende resultater
Ønsker du at opretholde et rent og indbydende hjem eller kontor i Odense? I denne artikel gennemgår vi de bedste tips og overvejelser i forbindelse med rengøring samt introducerer en effektiv løsning

Terrasse pavillon - skab dit eget fristed i haven
Drømmer du om en oase i din baghave, hvor du kan nyde en kop kaffe eller et godt måltid i det fri? En terrasse pavillon kan være den perfekte løsning for dig. I denne artikel vil vi udforske de mange

Bøjler - en essentiel del af din garderobe
Når det kommer til at organisere dit klædeskab, er bøjler en uundgåelig del af processen. Uanset om du bor alene eller har en stor familie, kan de rigtige bøjler gøre en kæmpe forskel i, hvordan din g

Micha vest - stilfulde veste til enhver anledning
En vest er et tidløst stykke tøj, der passer til mange forskellige stilarter og lejligheder. Micha veste skiller sig ud med deres elegante design og kvalitetsmateriale. I denne artikel udforsker vi, h

Oplev ultimativ afslapning med en massagestol
Vi lever i en travl verden, hvor stress og jag konstant presser os. En massagestol kan være svaret på dine drømme om afslapning. I denne artikel vil vi dykke ned i, hvordan en massagestol kan forbedre

Forståelse af finansielt lønsystem - en guide til finansielle virksomheder
I dagens moderne forretningsverden er et effektivt finansielt lønsystem afgørende for en bæredygtig økonomi og operationel succes. For finansielle virksomheder er det særligt vigtigt at have et system

Oplev charmen på gl tangegaard
Drømmer du om en autentisk, landlig oplevelse i hjertet af Danmark? Så er gl tangegaard et besøg værd. Denne artikel udforsker, hvad der gør gl tangegaard til en unik destination for både lokale

Zink til heste - vigtigt mineral for sundhed og præstation
Zink er et essentielt mineral for heste, der spiller en afgørende rolle i deres samlede helbred og præstation. Læs videre for at forstå hvorfor zink er så vitalt, hvad tegnene på zinkmangel kan være,

Pam - en dybdegående guide til effektiv produktadministration
Produktadministration er en central del af enhver virksomheds strategi, der søger at maksimere effektiviteten og minimere driftsomkostningerne. En moderne løsning, som mange virksomheder nu tager i br

Parterapeut odense - en vejen til et stærkt og kærligt forhold
Kunne dit parforhold drage nytte af nogle nye perspektiver og redskaber for at styrke kærligheden og forståelsen? I Odense findes der dygtige parterapeuter, der kan hjælpe jer med at navigere gennem u

Cassidy in overwatch 2 - the sharpshooting gunslinger
Since the launch of Overwatch 2 , many heroes have undergone significant changes to better fit the game's new dynamics. One such character is Cassidy, formerly known as McCree. Recognized for his s

Mirage - the holographic trickster of apex legends
In the fast-paced battle royale world of Apex Legends, a diverse roster of Legends offers unique abilities and gameplay styles. One of the most entertaining and deceptive characters in the game is

Duftposer - gør hjemmet frisk og indbydende
I en travl hverdag er der få ting, der kan glæde os mere end at komme hjem til et velduftende hjem. Med duftposer kan du nemt opnå en behagelig atmosfære i dit hjem, uanset om det er i klædeskabet, i

Yoga instruktør uddannelse - en rejse mod fordybelse og undervisning
Drømmer du om at dykke dybere ned i yogaens verden og dele din passion med andre? Overvejer du at tage en yoga instruktør uddannelse? I denne artikel vil vi guide dig gennem de vigtigste overvejelser

Rose quartz - betydning, anvendelse og fordele
Rose quartz er en af de mest populære krystaller inden for spiritualitet og holistisk helse. I denne artikel vil vi udforske dens betydning, forskellige anvendelsesmuligheder og hvordan du kan integre

Advokat svendborg - din guide til juridisk bistand i hjertet af fyn
Når du står overfor juridiske udfordringer i Svendborg, er det essentielt at finde den rette advokat, der kan sikre dine interesser og give dig den bedste rådgivning. I denne artikel vil vi introducer

League of legends news - the latest updates from the rift
League of Legends continues to evolve with each patch, improving gameplay and introducing exciting new content for players around the world. Whether you're a casual player or an aspiring pro, staying

Dotafire review
In the ever-evolving world of Dota 2, staying ahead with the latest strategies, hero builds, and item combinations is crucial for gamers who wish to up their game. Among several online resources aimed

Cryptocom coin - en dybdegående guide
Cryptoverdenen er i konstant udvikling, og blandt de mange tokens og valutaer, der tilbyder lovende investeringsmuligheder, befinder Cryptocom Coin (CRO) sig i rampelyset. I denne artikel vil vi dykke

Cykel til 3 årig - ideelle valg for dit barn
At vælge den rigtige cykel til en 3-årig kan være en stor beslutning. Denne artikel guider dig gennem nøgleovervejelser, så du kan finde en cykel, der er sikker, sjov og perfekt til dit barns behov. V

Høkasse - en guide til effektiv madlavning
Høkassen er en genial opfindelse, der gennem årene har hjulpet husstande med at spare energi og tilberede maden på en sund og miljøvenlig måde. I denne artikel vil vi udforske, hvad en høkasse er, hvo

Premier League betting tips
Premier League er en af verdens mest populære fodboldligaer, og det er ikke svært at forstå hvorfor. Med så mange talentfulde spillere og intense kampe, er det også blevet et populært emne for betting

Striktrøjer – din guide til varme og stilfulde tider
Striktrøjer er en uundværlig del af garderoben, især når temperaturen falder. I denne artikel vil vi udforske fordelene ved at bruge striktrøjer, hvordan du vælger den perfekte striktrøje og de nyeste

Effektivisering af beslutningsprocesser for indholdsskabere
Effektivisering af beslutningsprocesser for indholdsskabere Indholdsskabere står over for en række udfordringer i den digitale tidsalder, hvor hurtige og præcise beslutninger er afgørende for succe

Unlock competitive success with faceit finder
In the world of competitive gaming, knowing your strengths, weaknesses, and those of your opponents is essential. Whether you're a casual gamer aiming to improve or a seasoned esports enthusiast looki

Ifø toilet - købsguide & information
At vælge det rette toilet til dit hjem kan være en udfordring. Men med Ifø toilet kan du finde en løsning, der kombinerer kvalitet, design og funktionalitet. I denne artikel vil vi dykke ned i de fors

Pergola med skydetag - en alsidig løsning til dit udemiljø
Drømmer du om at skabe et fleksibelt og funktionelt udemiljø, der tilpasser sig de skiftende danske vejrforhold? En Pergola med skydetag er den perfekte løsning for dig. Denne innovative struktu

Hold styr på de vigtigste minder med billedfremkaldelse hos Frederikssund Foto
Hold styr på de vigtigste minder med billedfremkaldelse hos Frederikssund Foto I en digital tidsalder, hvor billeder ofte forbliver på skærme, åbner billedfremkaldelse en dør til en mere taktil opl

Gram køleskabe - En guide til det perfekte valg
Når det kommer til at vælge det rette køleskab til dit hjem, kan det være overvældende med de mange mærker, modeller og funktioner på markedet. Men med gram køleskabe , er du sikret et produkt af

Træpiller fyn - miljøvenligt brændsel til din bolig
Overvejer du træpiller som en bæredygtig opvarmningsløsning? På Fyn er der et væld af muligheder for at finde kvalitets træpiller, der ikke kun gavner miljøet, men også din varmeøkonomi. Læs videre fo

Alberto Fasciani - En verden af luksusfodtøj og stil
Når det kommer til luksusfodtøj, skiller alberto fasciani sig ud med enestående håndværk og stil. Denne artikel dykker ned i historien bag mærket, hvad der gør deres fodtøj så specielt, og hvorf

Luft til vand varmepumpe - effektiv opvarmning og besparelser
Overvejer du at skifte til en mere energi-effektiv opvarmningsløsning? En luft til vand varmepumpe kan være den perfekte løsning for dig. I denne artikel dykker vi ned i, hvordan varmepumper fungerer,

Ny hjemmeside i wordpress - En guide til succes
Drømmer du om at skabe en flot og funktionel ny hjemmeside i WordPress? Du er ikke alene. WordPress er et populært værktøj for små og store virksomheder, bloggere og iværksættere. I denne artikel vil

Firmatøj - din ultimative guide til professionel beklædning
Når det kommer til at skabe et professionelt image og styrke virksomhedens brand, spiller firmatøj en afgørende rolle. Denne artikel vil guide dig gennem fordelene ved firmatøj, hvordan du vælger det

Myway - din vej til personlig vækst og succes
I en verden, hvor mulighederne er mange og valgene ofte kan virke overvældende, er det vigtigt at have en klar vej og retning. Myway er en platform, der hjælper dig med at navigere gennem livet ved at

PLC - programmerbar logisk controller
Velkommen til vores udforskning af PLC, en nøglekomponent inden for industriel automation. Dette system har revolutioneret metoderne til kontrol og overvågning i produktionsmiljøer. I denne artikel vi

Varmepumper - Luft til vand: Effektiv og miljørigtig opvarmning
Overvejer du at forbedre dit hjems opvarmningssystem, men er usikker på, hvilken teknologi der passer bedst til dine behov? I denne artikel vil vi dykke ned i verdenen af varmepumper - luft til van

Akustik firma: Hvad skal du vide?
Akustikfirmaer spiller en afgørende rolle i at forbedre lydoplevelsen i mange forskellige miljøer. Uanset om du har brug for hjælp til at løse akustiske udfordringer i et åbent kontorlandskab, i dit h

Brugte luksusure – et indblik i en verden af tidløs elegance
Drømmer du om at eje et luksusur, men ønsker at finde en mere økonomisk adgangsvej ind i dette eksklusive univers? Brugte luksusure kan være svaret. I denne artikel vil vi udforske fordelene ved at kø

Plejesenge - En Guide til Comfort og Funktionalitet
Er du på udkig efter en plejeseng, der kan tilbyde både komfort og praktiske funktioner til dig eller en elsket? Plejesenge er essentielle for dem, der har brug for ekstra støtte i deres hverdag. I de

Alt, hvad du behøver at vide om jagtvesten
En jagtvest er en essentiel investering for enhver jæger, der ønsker at optimere oplevelsen i naturen. Det er ikke blot et simpelt stykke tøj, men et funktionelt og teknisk udstyr, der hjælper med at

Find de Bedste Konferencefaciliteter Fyn
Når det kommer til at vælge de rette konferencefaciliteter Fyn, er der mange faktorer, der spiller ind for at sikre en vellykket begivenhed. Et velvalgt sted kan gøre en afgørende forskel for deltager

Skift til et billigere elselskab – Så nemt er det at skifte el leverandør
Betaler du for meget for din strøm? Mange danskere har opdaget, at de faktisk kan spare betydelige beløb ved at skifte til et billigere elselskab. Siden 2003 har der været frit elvalg i Danmark, og de

Hvad er landmåler software, og hvorfor er det vigtigt?
Landmåling har været en essentiel del af infrastrukturprojekter, kortlægning og byggeprocesser i mange år. Den teknologiske udvikling har gjort det muligt for landmålere at arbejde mere præcist og eff

Styrk dit forhold med parterapi risskov - Aarhus
Parterapi er en effektiv metode til at løse udfordringer i et parforhold. I området Risskov nær Aarhus findes flere muligheder for par, der ønsker at forbedre deres forhold. Dette blogindlæg vil under

Find de bedste cykeldæk til enhver tur
Cykeldæk er hjertet af en cykel, der forbinder rytteren med vejen. At vælge de rigtige dæk kan gøre en kæmpe forskel i din cykeloplevelse, uanset om du pendler til arbejde, kører på mountainbike eller

Hvordan erhvervsrengøring kan transformere arbejdspladser og forbedre medarbejderproduktiviteten
Erhvervsrengøring er en essentiel service for virksomheder, der ønsker at opretholde et rent og sundt arbejdsmiljø. denne artikel dykker ned i, hvordan erhvervsrengøring kan forbedre arbejdspladsen og

Hvad du skal vide om shilajit og dets lovlighed i Danmark
Shilajit er et naturligt stof, der har fanget opmærksomheden hos mange, der søger sundhedsfordele fra naturlige midler. Det er kendt for at være rig på mineraler og har i århundreder været brugt i tra

Opdag de mange facetter af norsk garn
At udforske norsk garn kan være en rejse fyldt med farver og teksturer. For nybegyndere kan det virke som en labyrint af muligheder. Norsk garn tilbyder en rigdom af typer og materialer, hvilket gør

Oplev serendipity med bæredygtigt babytøj
Det er en glæde og en særegen oplevelse at have en nyfødt i hjemmet. En tid fyldt med både overvældende øjeblikke og uendelige beslutninger, især når det kommer til at vælge det rigtige tøj til den li

Grøn rengøring til fremtiden med Prime Clean
I en tid hvor bæredygtighed står højt på dagsordenen for mange virksomheder, kan det være svært at finde den rette balance mellem effektivitet og miljøansvar. Prime Clean Nordic tilbyder løsninger,

Effektiv støjreduktion med mobile akustikpaneler til åbne kontorlandskaber
I mange moderne virksomheder er åbne kontorlandskaber blevet normen. Selvom dette layout fremmer samarbejde og kommunikation, medfører det også udfordringer med akustikken. Støj fra kollegaers samtale

Opdag de skjulte historier i narrativ supervision
Supervision er en afgørende praksis inden for mange professionelle felter, men narrativ supervision adskiller sig ved sin unikke tilgang til at lytte til centrale historier og intentioner i komplekse

Sælg landejendom med succes
Sælg landejendom kan være en udfordrende opgave, men med den rette viden og planlægning kan processen blive meget lettere. Det handler om at forstå markedet, forberede ejendommen korrekt og navigere i

Gør dine vanddrømme til virkelighed med et blødgøringsanlæg
At have adgang til rent og kalkfrit vand er essentielt for ethvert hjem. Med et blødgøringsanlæg som SLIM SOFT eller LEYCO SOFT kan man opnå den bedste vandkvalitet uden besvær. Disse anlæg er kompa

Skab Magi i Dit Hjem med Vægrosetter
Vægrosetter er blevet et populært valg for dem, der ønsker at tilføje et kunstnerisk og stemningsfuldt touch til deres boligindretning. Disse dekorative væglamper kombinerer funktionalitet med æstetik

Skab et grønt paradis med kunstige hængeplanter
I en travl verden, hvor tid og plads ofte er en begrænsning, kan kunstige hængeplanter være den perfekte løsning til at bringe naturens skønhed ind i hjemmet. Denne blogpost vil udforske fordelene ved

Spar penge med billigt internet uden kompromis
Billigt Internet har vist sig at være en uundværlig ressource for både arbejde, underholdning og kommunikation. For mange mennesker er det vigtigt at finde en internetløsning, der passer til budgettet

Få styr på virksomhedens aktiver med effektiv asset management
Effektiv asset management er afgørende for at sikre, at en organisation kan spore og administrere sine aktiver på en organiseret og struktureret måde. Mange virksomheder står over for udfordringer,

Magnesiummangel hos heste er en skjult trussel
Heste er stærke dyr, men som alle levende væsener kræver de ordentlig ernæring for at trives. Magnesiummangel er en af de mest undervurderede problemer hos heste, og det kan have alvorlige konsekvense

Sådan vælger du det bedste mobilabonnement for dine behov
Mobilabonnementer er blevet en integreret del af dagligdagen. De giver mulighed for at foretage opkald, sende beskeder og surfe på internettet. Men hvordan vælger du det rigtige mobilabonnement blandt

Rejsetasker til kuffert – Den ultimative rejsepartner
Når man tænker på at pakke en rejsetaske til kuffert , opstår der en følelse af frihed og eventyr. Hver genstand i tasken repræsenterer en historie eller en drøm, der endnu ikke er realiseret. Hos No

HAY Reol: Funktionel elegance til dit hjem
HAY er kendt for at kombinere funktionalitet med moderne design, og deres reoler er ingen undtagelse. Med et skarpt øje for detaljer og en forståelse for nutidens boligindretning har HAY skabt reoler,

Sådan forebygger man en forkølelse
Når årstiderne skifter, og vejret bliver koldere og mere vådt, øges risikoen for at blive ramt af en forkølelse. Men hvordan forebygger man en forkølelse ? Selvom forkølelse ikke er en alvorlig sygdo

Få flere kundeemner med effektiv leadgenerering
At få nye kunder er afgørende for enhver virksomhed. Uanset om en virksomhed lige er startet eller har eksisteret i mange år, er tilgangen af nye kundeemner altid vigtig. Dette blogindlæg vil dykke ne

Den ultimative guide til støvsugere
Støvsugere er uundværlige redskaber i ethvert hjem. De gør rengøringen nem og effektiv, og med forskellige modeller og funktioner kan de tilpasses ethvert behov. Uanset om du har brug for en kraftig s

Sådan får radioreklame din virksomhed til at skille sig ud
Radioreklame er en kraftfuld måde at nå ud til en bred målgruppe på. Mere end 60% af alle danskere lytter til radio dagligt. Det gør radioreklame til en effektiv kanal for virksomheder, der ønsk

Nyeste trends indenfor mobiltelefoner
Nyeste trends indenfor mobiltelefoner Mobiltelefoner udvikler sig konstant og introducerer nye funktioner, der gør hverdagen lettere. Danske forbrugere har nu flere valgmuligheder end nogensinde før

Transformér dit rum med vægpaneler
I en tid, hvor boligindretning og æstetik spiller en væsentlig rolle i mange menneskers liv, er vægpaneler blevet en populær løsning. Vægpaneler er ikke blot en praktisk måde at dække vægge på; de t

De bedste tips til at vælge det perfekte kattehalsbånd
At finde det rigtige kattehalsbånd til din elskede kat kan virke som en udfordring. I denne blog vil vi gennemgå alt, hvad du behøver at vide for at træffe den bedste beslutning for din firbenede ve

Beskyt din virksomhed mod sikkerhedsbrud med disse essentielle tips
Flere danske og internationale virksomheder er gennem de sidste år blevet ramt af cyberangreb. De kriminelle infiltrerer virksomhedernes systemer, krypterer og stjæler følsomme data. Desværre ender ma

En verden af endoskoper - hvad du behøver at vide
Endoskoper er et fantastisk medicinsk værktøj, der har transformeret moderne medicin. Men hvad er endoskoper egentlig, og hvordan fungerer de? I denne blog vil vi udforske de mange facetter af endos

Den ultimative guide til sliberondeller til båd
At vedligeholde en båd kan være en krævende opgave, men med de rigtige værktøjer kan det blive meget lettere. En af de mest uundværlige redskaber til bådvedligeholdelse er sliberondeller . I denne gu

Forberedelse er nøglen
Inden du kaster dig ud i en køkkenrenovering, er det vigtigt at forberede dig grundigt. Gør dig klart, hvad dine behov og ønsker er, og sørg for at have et realistisk budget på plads. En køkkenrenove

Outdoor reklamer: Skab opmærksomhed og øg din synlighed
I en verden, hvor digital markedsføring dominerer, er det let at overse værdien af traditionelle marketingmetoder som outdoor reklamer . Men sandheden er, at outdoor reklamer fortsat spiller en afgør

Bliv klogere på Sectros udvalg af lygter i højeste kvalitet
Det er afgørende at have pålideligt udstyr, der kan oplyse din vej og sikre din sikkerhed, uanset om du arbejder som vagt, i sikkerhedsbranchen, eller blot har brug for kvalitetsbelysning til personli

Merci Filcolana: Kvalitetsgarn til kreative projekter
Merci Filcolana er et populært garnmærke, kendt for sin høje kvalitet og alsidighed. Filcolana, en anerkendt dansk garnproducent, har skabt Merci-garnet, der består af en blanding af bomuld og uld. De

Oplev magien ved golden akrylmaling
Akrylmaling har revolutioneret kunstverdenen siden dens fremkomst, og blandt de mange mærker på markedet skiller Golden akrylmaling sig ud som en favorit blandt kunstnere. Dens alsidighed, høje pigm

Guide til køb af brugt motionscykel
Når du beslutter dig for at investere i en motionscykel, kan det være en god idé at overveje en brugt model. En brugt motionscykel kan være lige så effektiv som en ny, men til en brøkdel af prisen.

Skab magi med keramik perler
Keramik perler har i århundreder været brugt til at skabe smukke smykker, dekorationer og endda kunstværker. Disse små, men kraftfulde elementer af design har evnen til at transformere ethvert projekt

Alt om førerhusdele: En guide til at vælge de rette komponenter
Når det kommer til vedligeholdelse og opgradering af køretøjer, spiller førerhusdele en afgørende rolle i at sikre komfort, sikkerhed og ydeevne. I denne guide dykker vi ned i verdenen af førerhusdel

Den ultimative guide til valg af den rette dispenser til sæbe
I en verden, hvor hygiejne er blevet mere vigtig end nogensinde, spiller en god dispenser til sæbe en afgørende rolle i vores daglige rutiner. Det er ikke kun et spørgsmål om renlighed, men også om ko

Vælg det rette badeforhæng til dit badeværelse
Når det kommer til at indrette dit badeværelse, er valget af det rette badeforhæng en beslutning, der ikke bør tages let. Et badeforhæng er ikke kun praktisk ved at holde vand væk fra resten af bade

Byg selv stol: En guide til den kreative håndværker
At bygge sin egen stol er ikke blot en fantastisk måde at tilføje et personligt præg til hjemmet på; det er også en yderst tilfredsstillende proces, der kan give en dyb følelse af stolthed og bedrift.

Spande med låg - En essentiel sikkerhedskomponent i arbejdet
I dagens arbejdsmiljø er det af højeste vigtighed at sikre, at alle sikkerhedsprotokoller og -foranstaltninger følges nøje. En ofte overset, men afgørende komponent i dette arbejde, er brugen af span

Få hjælp til bekæmpelse af mus
Når mus invaderer ens hjem eller virksomhed, kan det være en stor udfordring og kilde til frustration. Mus kan forårsage skader på ejendom, sprede sygdomme og forårsage ubehag for beboere eller ansatt

Uldtrøje herre - et alsidigt valg til mænd
Uldtrøje herre er en tidløs klassiker, der har genvundet sin popularitet i de seneste år. Den er ikke kun varm og behagelig, men også utroligt alsidig og kan styles på utallige måder. Uanset om du fo

Udforsk det bedste i fugeværktøj hos Murergrej.dk
Opdag mulighederne med professionelt fugeværktøj Hos Murergrej.dk finder du et omfattende udvalg af fugeværktøj, der møder selv de mest krævende behov inden for murerbranchen. Deres sortiment spænd

Geoceller: Den innovative løsning til jordstabilisering og erosionssikring
I en verden, hvor behovet for bæredygtig infrastruktur og miljøbeskyttelse bliver stadig mere presserende, er geoceller blevet en stigende populær løsning. Disse avancerede strukturer af geotekstile

Redgreen brandet: tidløs skandinavisk stil til ethvert øjeblik
I den pulserende verden af mode og design har det danske brand Redgreen markeret sig som en bastion af tidløs skandinavisk stil. Med deres rødder solidt plantet i dansk designtradition, har Redgreen s

Plexiglas rør: En klar og holdbar løsning til diverse applikationer
Plexiglas rør, også kendt som akrylrør, er cylindriske rør lavet af transparent polymethylmethacrylat (PMMA), kendt under varemærket Plexiglas. Disse rør er kendetegnet ved deres enestående klarhed, h

Fibertex: Alsidige fiberbaserede materialer til talrige formål
Fibertex er et specialiseret fiberbaseret materiale, der produceres af flere virksomheder rundt om i verden. Disse materialer er kendt for deres alsidighed, holdbarhed og brede anvendelsesområder i en

Håndklædeark: Den uundværlige hygiejnekomponent
Håndklædeark er en essentiel del af hverdagen, både i hjemmet og i offentlige miljøer. Disse tynde, absorberende stykker stof har en lang historie og en række anvendelser, der strækker sig langt ud ov

Depotrum Aarhus: Forøg din livskvalitet med ekstra opbevaringsplads
I en tid, hvor urbaniseringen vokser, og hjemmets kvadratmeter bliver en fantastisk sjældenhed, er det ikke underligt, at mange af os er på jagt efter plads. Løsningen ligger i Aarhus hos depotrum Aa

Cykler fra Norden Bikes: en klassisk nostalgi med moderne præcision
Norden Bikes cykler bringer den tidløse elegance af retro-cykeldesign ind i det 21. århundrede med deres karakteristiske nordiske stil og skarpe, moderne detaljer. Hvert element af en Norden-cykel er

Opdag luksus og komfort: en kontinentalseng 140x200
En kontinentalseng 140x201 er en perfekt blanding af komfort, funktionalitet og æstetik, der tilbyder en luksuriøs soveoplevelse og maksimal støtte. Lad os udforske de mange fordele ved denne ideell

Fiksering af fibre: En vigtig proces i tekstilindustrien
Fiksering af fibre er en afgørende proces i tekstilindustrien, hvorved farve og kemikalier sikres at blive fastgjort til tekstilmaterialer på en holdbar måde. Denne proces er afgørende for at opnå far

Rynken billede hos tandlægen: Hvad du har brug for at vide
I den moderne tandpleje er billeddiagnostik afgørende for en nøjagtig diagnose og effektiv behandlingsplanlægning. Et rynken billede eller røntgenbillede, spiller en central rolle i at give tandlæger

Et spark af håb for armen: livet gennem sponsorbarn
Armen er ikke enestående. Faktisk er armens liv en prøvelse delt af mange andre børn i hans position. Han er et eksempel på de børn, som i en ung alder har set mere kaos og usikkerhed, end de fleste v

Hvor vigtigt det er at vælge den rette ejendomsadministrator odensei odense
Har du nogensinde overvejet, hvordan en ejendomsadministrator odense kan påvirke den løbende håndtering af din ejendoms praktiske og økonomiske aspekter? Valget af en ejendomsadministrator odense

Tyske kurser oversigt
Tysk er et sprog, der åbner døre til en verden af kultur, historie og forretning. At lære tysk er ikke blot en investering i din personlige udvikling, men også en værdifuld kompetence på det internati

Kvalitetstræpiller 8 mm – Den miljøvenlige opvarmningsløsning
Træpiller har vundet enorm popularitet som en bæredygtig og økonomisk opvarmningsløsning. På Ewers Energi forpligter vi os til at levere træpiller af højeste kvalitet, og vores træpiller 8 mm er ing

Det ultimative guide til Epson blækpatroner
Når det kommer til printning, er kvaliteten af dine blækpatroner afgørende for at sikre, at dine dokumenter og billeder ser professionelle ud. Epson blækpatroner er blandt de mest anerkendte i branc

Firmajulefrokoster i Jylland
Julen er tiden for hygge, samvær og traditioner. Og hvad er mere traditionelt end en god, gammeldags julefrokost? Især i danske virksomheder er firmajulefrokosten et af årets højdepunkter; en unik mul

Skab magiske øjeblikke med den perfekte firmafest
Planlægning af en firmafest kan ofte være en stor udfordring. Der skal tages hensyn til mange forskellige faktorer for at sikre, at festen bliver en succes, der taler til alle sanser. Det kræver et ev

Vælg det perfekte spisebord til dit hjem
At finde det rette spisebord er ikke bare et spørgsmål om at anskaffe sig en flad overflade at spise fra. Det er en investering i dit hjem og den atmosfære, som spisestuen skal emme af. Derfor er det

Merino uld undertøj: den ultimative beklædning for outdoor entusiaster
Merino uld undertøj har vundet stor anerkendelse blandt outdoor entusiaster verden over. Den unikke blanding af lethed, varme og åndbarhed gør merino uld til et oplagt valg for alle, der søger komfor

Badedragt til børn: en guide til forældre
Sommeren nærmer sig, og det betyder en ting for de fleste familier med børn – det er på tide at komme ud og svømme! En god badedragt til børn er vigtig for at sikre, at dine børn kan nyde vandet og

Guide til valg af de bedste badehåndklæder til dit hjem
At vælge det rette badehåndklæde er ikke kun et spørgsmål om farve eller mønster – det handler om komfort, funktionalitet og stil. I denne guide dykker vi ned i, hvad der gør et badehåndklæde ideelt f

Top 5 Ladestandere i Danmark: Find Den Bedste Oplader til Dit Elbilkøretøj
Elbilen har indtaget Danmarks gader, og med denne bølge af grøn transport følger behovet for effektive ladestandere. For elbilsejere er det vigtigt at finde en ladestander, der ikke bare er driftssikk

Overløbsregistrering til bygværker og pumpebrønde
Overløbshændelser i forbindelse med bygværker og pumpebrønde er en betydningsfuld faktor, når det drejer sig om miljøbeskyttelse og byggebranchens ansvar. Overløb kan medføre alvorlige konsekvenser fo

PPC marketing – Brug din markedsføring fornuftigt
PPC-marketing er en meget populær og anerkendt disciplin når det kommer til at markedsføre sig online. Det er alle typer af virksomheder, som kan drage nytte af PPC-marketing. Det kan være alt fra en

Sådan har CMS-systemer udviklet sig over tid
Annonce Hjemmesider har efterhånden eksisteret i en længere årrække, og i takt med den digitale udvikling, så blev de operative systemer, der hjalp virksomheden med at opretholde og opdatere hjemmes

3 tips til bedre kundekommunikation
Dette indhold er sponsoreret I en dagligdag drevet af teknologi og sociale medier er kommunikationen med kunder og forbrugere i høj grad blevet digitaliseret. Mange virksomheder bruger e-mails, ny

Det robuste Data Warehouse
Dette indhold er sponsoreret For de fleste virksomheder, stiger mængden af datakilder, og med det også krav og ønsker til dataorienteret funktionalitet. Her er der blandt andet tale om historik på

Gør din borddækning unik med et stel
Har du en porcelænssamling? Eller måske også andre antikviteter, som dekoration på bordet – eller i hjemmet? Så er der ingen tvivl om, at det giver et væld af muligheder for personligt særpræg. Stel u

Unik kvalitet i et Vestfrost vinkøleskab
Nyeste Vestfrost vinkøleskabe kan prale af at leve op til de højeste standarder, Vestfrost kender til på området. I mere end 25 år har Vestfrost produceret vinkøleskabe i Danmark, nærmere betegnet Esb

Gør din arbejdsplads mere behagelig med nogle vibrationsdæmpere
Du er sikkert kommet til det helt rigtige sted, hvis du arbejder med maskiner. Vibrationsdæmpere kan undgår unødvendig larm i den daglige driftsproces og dermed mindske risikoen for vibratiosrelatered

Alt engangsservice du behøver til at holde fest
I mange år har engangsservice været meget populært til sommerfester, julefrokoster og andre lejligheder. Engangsservice er billige engangsalternativer til dagligdags service, som kan bruges én gang,

Lys hjemmet op med den rette lampe
Det kan virke som noget af en kunstform at indrette sit hjem med de helt rette møbler, designs, faconer og farver. Men et rigtig godt trick er at fokusere på lyset i hjemmet. Lamper og deres design be

Vælg en brætspil og invitere familien over til en god omgang søndagshygge
Brætspil er et spil, som spilles på et bord. Brætspillet indeholder typisk en form for brikker, som flyttes rundt på en overflade eller et bræt. Brætspillet kan være strategisk, hvor det handler om at

Køb Kinetic Sand hos Legebyen.dk
Legebyen.dk har 25 års erfaring i branchen og derfor styr på legetøj! Forretningen er kendt for dens store udvalg af kvalitetslegetøj, der egner sig til både private og institutioner. Køb for eksempel

YouSave.dk: Alt i belysning og spots fra anerkendte mærker som Daxtor og Nordtronic
YouSave.dk har et stort udvalg af tech og elektronik. Du kan bl.a. finde smarte spots fra Daxtor og Nordtronic. Læs mere her om spot og lamper. Daxtor producerer kvalitetsspots til hjemmet Yo

Deltag i en online maskinauktion hos Kapow
Gør noget godt for dig selv og miljøet ved at deltage i en eller flere af de skønne online maskinauktioner hos www.kapow.eu. Her har mange tilfredse kunder fundet brugte maskiner til landbrug, industr

Trend cts hjæper dig med at finde den rette løsning
trend cts-systemer er den mest effektive måde at regulere energiforbruget i din kommercielle eller industrielle bygning på. Med et trend cts-system kan du forbedre dit indeklima, spare på regningerne

Naturbutikken har DOF BirdLife-teleskoper
Naturbutikken forhandler landets største og bedste udvalg af kikkerter og teleskoper til ornitologer og fugleentusiaster. Dette sker både gennem den populære webshop og den velbesøgte butik i Københav

Få hjælp med monteringen af varmepumpe luft til vand
luft-til-vand-varmepumper er en fantastisk måde at opvarme dit hjem på, samtidig med at du sparer på energiomkostningerne. luft-til-vand-varmepumper fungerer ved at trække luft gennem en varmeveksler

Beskyt dine øjne med Sikkerhedsbriller med styrke
Sikkerhedsbriller med styrke er et vigtigt stykke personligt beskyttelsesudstyr (PPE), der kan hjælpe med at beskytte dine øjne mod skader. Uanset om du arbejder i et laboratorium eller på en fabrik,

Forbedre din have med Teak havemøbler
Havemøbler i teak er en fantastisk måde at forbedre din have på. Teak er et stærkt og holdbart træ, der er perfekt til udendørs brug. Det er også let at rengøre og vedligeholde, hvilket gør det til et

Find den rette elcykel her
Hvis du leder efter et alternativ til offentlig transport eller din bil, kan en elcykel (e-bike) være en god mulighed. E-bikes har alle fordelene ved en almindelig cykel, men med den ekstra bonus, a

Mobilcovers er en god beskyttelse til dine dyre telefoner
Hvis du er på udkig efter mobilcovers, der er både billige og stilfulde, kan du finde et stort udvalg af dem online! Der er et stort udvalg af forskellige designs at vælge imellem, så du er sikker på

Luft til vand varmepumpe – Et sikkert valg
Er du på udkig efter 2022 varmepumper? Så er du altså kommet til det helt rette sted! På hjemmesiden finder du nemlig et stort udvalg af luft til vand varmepumpe, der alle er i høj kvalitet. At skifte

Tilføj noget spænding til hverdagen med en el knallert
Mangler du lidt spænding eller fart i tilværelsen? Så er en el knallert fra Talaria måske løsningen. Talaria Sting offroad el knallert er en kraftfuld og spontan løsning til din hverdag. Med sin elmot

Få et spejl med lys fra Spejlfabrikken
På www.spejlfabrikken.dk finder du det skønneste udvalg af moderne og funktionelle spejle til dit badeværelse. Design selv, eller vælg et spejl fra webshoppen. Vælg et spejl med lys med forskellige sm

Tag til skrothandler med alt det, du ikke ved hvad du gør af
Det er ikke altid nemt at vide, hvad man stiller op med alle de ting, der kan hobe sig op løbende. For uanset hvor meget du end måtte forsøge at tage hensyn til det, så er det tvivlsomt at du helt kan

Din guide til tovværk
Står du og mangler tovværk til din båd, så ikke tøv med at hoppe ind på www.shipshape.dk og tjek deres store udvalg af tovværk ud. De har alle former og typer af tovværk til netop din båd eller situ

Få din virksomhed bredere ud
Hvem vil ikke gerne optimere sin virksomhed? Det er altid sjovere at yde og skabe bedre resultater. Det kan gøres på mange måder. Det er altid sjovt at slå sine konkurrenter af banen med en hurtig, in

Med striktrøjer kan alle i familien holde sig varme!
Som enhver strikkeentusiast ved, er det vigtigt at have det rigtige værktøj for at opnå den perfekte finish. Her hos skovhuus strikning er de stolte af deres udvalg af strikkepinde, garn og andet tilb

Overvej et pantebrevslån til at finansiere dit huskøb
Pantebrevslån er en type lån, der specifikt anvendes til køb af fast ejendom, typisk et hus. Ejendommen tjener som sikkerhed for lånet, hvilket betyder, at långiveren kan tage den i besiddelse, hvis l

Få skab en fantastisk stemning med et barbord til dit hjem eller din forsamling
Et barbord er et populært valg i mange hjem, fordi det er en elegant og stilfuld måde at indrette et opholdsrum på. De placeres ofte i stuen eller i arbejdsværelset, men kan også bruges i andre område

Vis hvem du er med dit Iphone cover
Et Iphone cover er designet til at beskytte din iphone mod skader og slitage. Afhængigt af hvilken type iphone cover du vælger, kan det give forskellige grader af beskyttelse mod stød, ridser, vands

Dit næste stykke værktøj
Går du med en tømrer i maven? Måske du endda er udlært, og nyder at fifle med dine egne projekter derhjemme? Der er flere gode grunde til at unde sig selv nye værktøjer. De pynter ikke kun på værksted

Brug for en printer i firmæt?
Uanset hvor meget digitaliseres, så vil der altid være behov for printere i mange virksomheder. Her tænkes der ikke blot på grafiske virksomheder, der selvfølgelig skal have printere til at kunne leve

Få lavet forsikringsskader på bil hos VejlesAuto
Lige meget om din bil trænger til et serviceeftersyn, om du har været uheldig at få en skade på bilen eller noget helt tredje, så står www.vejlesauto.dk klar til at hjælpe dig. Den imponerende mekanik

Gode råd til dig, der netop er kommet til skade
Hvis du er kommet til skade, og har fået slået dig lidt, er det noget, der kan være enormt frustrerende. Måske du er væltet på cyklen, eller er kommet til at vride om på din ankel. Uanset hvad der er

En hifi forstærker er en vigtig komponent i ethvert lydsystem
Hifi forstærker er et uundværligt led i lydkæden. Ved at forstærke og forstærke et signal er hifi-forstærkere afgørende for at få den bedste ydelse ud af ethvert lydsystem, uanset om det er et sofisti

Få hjælp til administration af lejeboliger
Ejer du boliger, der udlejes? Så ved du også, hvor meget papirarbejde, der følger med den slags. For nogle er det en enkelt bolig, der udlejes – for andre er boliger en investering, og I har flere for

Automatisk kladde 2
Test

Navigering i det digitale landskab: De bedste it-løsninger til succesfulde virksomheder
I dagens hurtige og stærkt konkurrenceprægede forretningsmiljø er det afgørende for succes at have de rigtige it-løsninger på plads. Fra cloud-tjenester og e-handelsplatforme til automatisk fakturahån

Blæk eller laser? Sådan vælger du den bedste printer til dine behov
Når det drejer sig om udskrivning af dokumenter, er der to hovedtyper af printere at vælge imellem: blækprintere og laserprintere. Begge har deres egne unikke funktioner og fordele, og det er vigtigt

Billige måltidskasser online
Det kan ofte godt blive en jungle at finde rundt i hvilken billig måltidskasse man skal vælge online! Men det behøver det ikke at være, for vi har samlet alle de bedste billige måltidskasser et sted

Sådan kan din puls måles
Pulsen er en vigtig måleenhed både for dig selv og lægen. Din hvilepuls giver nemlig et godt indblik i, hvordan dit velvære er, samt din form. Men hvordan kan du selv måle din puls, og hvordan måler l

Varmepumpe service er vigtig for den fungere optimalt
Service af varmepumper er en vigtig del af at sikre effektiviteten, sikkerheden og levetiden for dit varmepumpesystem. Vedligeholdelsesprocessen begynder typisk med, at en professionel tekniker udføre

Granatæble giver dig mange fordele
Granatæbler er en unik og gammel frugt med en lang historie rundt om i verden. Det menes, at den blev dyrket så tidligt som 4.000 f.Kr. i det nuværende Iran. Siden da har den været en vigtig del af ma

Tælle kalorier – hvad du skal vide
Har du nogensinde spekuleret på, hvad en kalorie er, og hvordan det er relateret til din kost? Hvis ja, så er du ikke alene. At tælle kalorier er en vigtig del af en sund livsstil, men at forstå dem

Sådan undgår du tørre og røde hænder med den perfekte håndcreme
For mange af os er det at fugte vores hænder en daglig opgave, som er vigtig for at holde vores hud sund og hydreret. Men med så mange forskellige mærker, ingredienser og typer af håndcremer til rådig

Køb mange forskellige Clinique produkter hos BEAUTYCOS
Clinique er et kosmetik- og hudplejebrand, der blev grundlagt i 1968. Det er en del af Estée Lauder Companies og er blevet en af de mest populære linjer af skønhedsprodukter i verden. Mærket tilbyder

4 grunde til, at en førstegangs boligkøber bør få en komplet køberrådgivning.
At købe et hjem er en stor forpligtelse, og det kan være en overvældende proces. Som førstegangskøber af en bolig er der mange juridiske overvejelser, som kræver vigtige beslutninger. Det er vigtigt a

En omfattende guide til teleslyngeanlæg til hørehæmmede
For personer med nedsat hørelse er det vigtigt at have adgang til et pålideligt og effektivt teleslyngeanlæg. Takket være teleslynge-teknologien kan mange mennesker nyde samtaler, møder og arrangement

Hvad er Facility Management, og hvorfor er det vigtigt?
Facility Management er en vigtig del af enhver succesfuld virksomhed. Den omfatter planlægning, koordinering og vedligeholdelse af alle aspekter af en virksomheds faciliteter. Dette omfatter alt f

Lej et festtelt og slip dine bekymringer!
Uanset om du fejrer et bryllup, en fødselsdag eller en anden speciel lejlighed, kan det at leje et telt gøre hele forskellen i din begivenheds succes. Et telt er en stor teltlignende struktur, der k

Gør dit hjem mere funktionelt
Dette indhold er sponsoreret Der er mange måder, hvorpå du kan gøre dit hjem mere funktionelt og give det et frisk pust. Et godt sted at starte er ved at overveje, hvilke funktioner de forskellige r

Find den rigtige tv-pakke til dig
Med så mange forskellige tv-pakker til rådighed kan det være svært at beslutte, hvilken pakke der er bedst for dig. Heldigvis kan du med lidt research og lidt snilde finde den perfekte pakke, der opfy

Bedre nætter
Bedre nætter er en dansk virksomhed, der er specialiseret i at levere kvalitets senge og madrasser til danskerne. Virksomheden blev grundlagt i 2014 med en mission om at forbedre folks søvnkvalitet ve

Hvorfor du bør overveje en 24-timers elektriker
Når du har brug for en elektriker, er tiden af afgørende betydning. Derfor er det vigtigt at vide, hvem der kan yde service samme dag, når du har en nødsituation. En elektriker døgnvagt kan være dit b

Smøring af landbrugsmaskiner som du kan få gavn af
For landmænd og landbrugsprofessionelle er korrekt vedligeholdelse og vedligeholdelse af deres maskiner afgørende. Dette omfatter smøring af de bevægelige dele på maskinerne for at sikre optimal ydeev

Hvad du skal vide om havetraktorer
Havetraktorer er specialiseret i at være din arbejdshest til udendørs opgaver. Deres kraftige motorer, holdbare rammer og alsidige redskaber gør dem i stand til at håndtere en lang række projekter. Ua

Succesfulde virksomheder: Styrken ved pålidelige it- og cybersikkerhedsløsninger i dagens digitale landskab
I dagens digitale tidsalder er virksomheder af alle størrelser stærkt afhængige af it-løsninger og cybersikkerhed for at beskytte deres følsomme oplysninger og data. Betydningen af pålidelige it-løsni

Strømline dine projekter: Styrken ved projektstyringssoftware
Projektstyringssoftware er blevet et vigtigt værktøj for virksomheder i alle størrelser og brancher. Det er en softwareapplikation, der gør det muligt for organisationer at planlægge, spore og styre d

Segboards og gokarts: Den ultimative sjov for børn
Segboards og gokarts er begge populære legetøj blandt børn. Ved at kombinere disse to former for legetøj kan man skabe en sjov og spændende oplevelse for børn. I denne artikel vil vi undersøge, hvorfo

Skabelse af et inspirerende atelier: En guide til indretning af dit grafiske arbejdsområde
Hvis du driver en virksomhed, der leverer grafiske designtjenester, er det vigtigt at have et veludstyret og velassorteret kontor for at sikre, at dit team kan arbejde effektivt og producere arbejde a

Drømmer du om at åbne et catering-firma?
Forestil dig at eje en virksomhed, som gør massevis af mennesker glade hver eneste dag. Mad er en central del af alle menneskers hverdag. Vi skal have næring før vores menneskelige maskine kan klare s

Sådan tilpasser du din virksomhed til markedsføring i Norge
Norge er et land med en unik kultur og en stærk national identitet. Hvis du ønsker at opnå succes med din markedsføring i Norge , er det vigtigt at forstå disse forskelle og tilpasse din tilgang de

Gem dit fjernsyn, når du ikke bruger det: Prøv en TV lift
Hvis du godt kan lide at se fjernsyn, men ikke synes, at TV’et passer særlig godt ind i resten af indretningen i dit hjem, så har du nu mulighed for at gøre noget ved problemet. Med en TV lift fra tvo

Sådan arrangerer du nemt dit eget LAN-party
Når du skal arrangere et godt LAN-party, kræver det ofte mere end blot at gøre plads til alle dine gæsters computere. Der kan nemlig også være nogle andre omstændigheder, du kan tage hensyn til for at

Tips til at vælge den rigtige bank til at investere i spiludstyr
Investering i spiludstyr kan være et lukrativt foretagende, men det er afgørende at vælge den rigtige bank for at maksimere dit afkast. Ved at følge disse retningslinjer kan du navigere i det finansie

Få styr på din virksomheds regnskaber med et online regnskabsprogram
Det kan være svært at holde styr på dine regnskaber, når du driver en virksomhed. Derfor er det vigtigt at have et godt overblik og kunne følge med i økonomien. Et online regnskabsprogram giver dig mu

Alt hvad du behøver at vide om plus pige tøj
Plus size mode har længe været subtiliseret og ofte ignoreret i modeindustrien, men heldigvis ser det ud til, at det er ved at ændre sig. Plus pige tøj er designet til kvinder med kurver, og i dagens

Alt, hvad du behøver at vide om LED-lys
I dagens verden er teknologi og innovation nogle af de vigtigste faktorer, når vi taler om bekvemmelighed og energibesparelser. En af de store innovationer i belysningsteknologi er uden tvivl LED-lyse

Batterier til el-scootere: Kraft til bevægelse og bæredygtighed
I dagens travle bymiljøer bliver el-scootere mere og mere populære som et praktisk og miljøvenligt transportmiddel. Disse kompakte køretøjer tilbyder bekvemmelighed og hurtig mobilitet uden at foruren

Hvorfor du skal vælge et mentorforløb hos Webshopskolen.dk.
At nå ens mål og realisere sit fulde potentiale kan være en udfordrende rejse. Men heldigvis er der en effektiv måde at accelerere sin udvikling på – gennem et mentorforløb. Et mentorforløb er en unik

Erobring af teknologiens verden: hvor innovation skaber muligheder
Du træder ind i en verden af uendelige muligheder, hvor innovation og teknologi forenes for at forvandle vores hverdag. Velkommen til et eksklusivt indblik i en revolutionerende æra, hvor vores liv på

Opdag de bedste træpiller til din opvarmning
Når det kommer til opvarmning med træpiller, er kvaliteten af brændstoffet afgørende for effektiviteten og pålideligheden af dit varmesystem. Med det brede udvalg af træpiller på markedet kan det dog

Skal du have en elektronisk dørlås i dit hjem?
De fleste boligejere er med al sandsynlighed interesseret i, at deres hjem er så sikkert som muligt. Dette involverer selvfølgelig en god lås, der kan holde indbrudstyve og lignende ude. I dag er de

3 ting du kan lave på computeren, hvis du trænger til et afbræk
I en travl verden, hvor computere ofte fungerer som vores primære arbejdsredskab, er det vigtigt at huske på, at de også kan bruges til mere end bare arbejde og produktivitet. Hvis du trænger til et a

Hvilken brilleform passer til dit ansigt?
Der findes et stort og bredt udvalg af briller, stel etc., og derfor kan det være noget af en jungle, når du skal finde nye briller! Det er helt forståeligt, at du gerne vil finde de briller, der klæd

Byggetilladelse og ingeniørens rolle – Hvad du skal vide før du starter dit byggeprojekt
At bygge sit eget hjem eller opføre en virksomhedsbygning er noget af det mest spændende, man kan foretage sig. Men det kan også være en udfordring at navigere i byggelovgivningen og de krav, som komm

Pantebrev: den skjulte skat på din boligfinansiering
Når vi drømmer om at købe vores drømmehus, er det vigtigt at forstå de forskellige aspekter af boligfinansiering. Et af de centrale begreber, der ofte dukker op i denne sammenhæng, er “pantebrev.” I d

Gør dit look unikt med Ørering vedhæng
Øreringe er en fantastisk måde at pynte sig selv og skabe et personligt look på. Men nogle gange har du brug for lidt ekstra flair til at gøre dine øreringe endnu mere unikke og personlige. Her kommer

Ulemperne ved at sælge bil
At sælg din bil kan være en udfordring for mange mennesker. Der er mange ting at overveje og faktorer at tage hensyn til, især når man ønsker at få den bedst mulige pris. Desværre er der også nogle

Danmarks Bedste Destinationswebshop for Familien
I en travl verden, hvor online shopping er blevet en integreret del af vores liv, er det afgørende at finde en pålidelig webshop, der kan imødekomme alle familiens behov. Satana.dk , en førende dansk

El ingeniør: Mestre af elektrisk teknologi og innovation
El ingeniører spiller en central rolle i vores moderne verden ved at designe, implementere og vedligeholde elektriske systemer, der driver alt fra vores hjem til komplekse industrielle anlæg. Deres ek

Erhvervsabonnementer: Effektiv Kommunikation for Virksomheder
Effektiv kommunikation er en hjørnesten i enhver succesfuld virksomhed. Erhvervsabonnementer til mobiltelefoni spiller en afgørende rolle i at opretholde en smidig kommunikation inden for virksomhed

Historien bag en flytning
At flytte kan være både spændende og udfordrende på samme tid. For nogle mennesker kan det føles som en mulighed for at starte på en frisk, mens andre kan opleve det som en følelsesmæssig belastning.

Gennemkørsel Forbudt
Skilte er en vigtig del af vejinfrastrukturen, og de tjener til at regulere trafikken på en sikker måde. Et af de mest kendte og anvendte skilte er “Gennemkørsel Forbudt,” der markerer områder, hvor

Elektriker i Kolding: Din Partner for Elektriske Løsninger
Når det kommer til elektriske udfordringer i hjemmet eller virksomheden, er en pålidelig og dygtig elektriker af afgørende betydning. I Kolding og omegn er elektrikere specialister i at levere elektri

De bedste grunde til at investere i Micha Bukser
Når det kommer til det ultimative i kvalitet og stil er Micha Bukser en klar favorit blandt kvinder. Hvis du ønsker at være stilfuld og komfortabel på samme tid, så skal du investere i et par af de læ

Teknologi Revolutionerer Hjemmet: Smart Udstyr Gør Livet Lettere
I dagens moderne verden spiller teknologi en afgørende rolle i vores daglige liv. Den hastige udvikling af smart udstyr har transformeret vores hjem og gjort dem mere intelligente end nogensinde før

Derfor bør du købe undertøj til hele familien hos Intimo!
Undertøj er en af de grundlæggende nødvendigheder i vores garderobe, men det er også en af de mest oversete. Hvis undertøjet ikke sidder ordentligt, kan vi føle os ukomfortable hele dagen. Derfor

Professionel Rengøring: Serwiz gør Rent og Skinnende!
En af de største udfordringer i enhver virksomhed eller husholdning er at holde stedet rent og præsentabelt. Uanset om det er gulvet, badeværelset eller kontorstolen, så kræver det tid og ressourcer a

ABC Plakat og Alfabetplakat: Læring og Dekoration i Ét
ABC-plakater og alfabetplakater er mere end bare dekorative elementer på børneværelset. De er en værdifuld pædagogisk ressource, der hjælper børn med at lære alfabetet, bogstavernes former og de grund

Accessories dit Streetwear: Tilføj personlighed til din stil
Accessories er en nøgle til at skabe en personlig og styret udseende i alle stilarter, men især i streetwear. Det handler om at tilføje en personlig berøring, der kan adskille dig fra masserne, og sam

Køkkenknive – den ultimative køkkenkammerat
Hvem har ikke brug for gode Køkkenknive? Hverdagen i køkkenet ville være helt umulig uden en ordentlig kniv. En Køkkenknive er nok den mest alsidige kniv, du kan have i dit køkkengrej, fordi den kan b

Den Magiske Verden af Radioreklame
Radioreklamer har en unik evne til at forvandle øjeblikke af stilhed til magiske øjeblikke af inspiration. I denne klangfulde rejse vil der blive udforsket den fascinerende verden af radioreklamer og

Et solcellepanel på taget? – Spar penge og reducer dit CO2-aftryk
I dag er interessen for bæredygtige løsninger og grøn omstilling stigende. Et solcelleanlæg på taget af dit hus kan være én af de smarte løsninger, der både kan spare dig for penge og reducere dit kli

Træbeskyttelse: Sådan sikrer du, at dit træ holder i mange år
At have smukt træværk i haven eller på terrassen kan være en sand fornøjelse. Men for at det kan holde i mange år, er det afgørende at beskytte træet mod vejr og vind. For mange er grundmaling og træ

Støbejernsgryder: Tidløs Kvalitet til Madlavning
Støbejernsgryder har gennem årtier været symbolet på robusthed og pålidelighed i køkkenet. Disse gryder har en unik evne til at holde på varmen og fordele den jævnt, hvilket gør dem uundværlige i enh

Bambus Undertøj: Fordelene ved Bambusviskose
Bambusviskose er blevet en populær trend i modeindustrien, især når det kommer til undertøj. Dette miljøvenlige materiale har flere fordele i forhold til traditionelle bomuldsvarianter. Bambus undertø

Sådan vælger du den bedste gåvogn til dit barn
En gåvogn kan være en sjov og underholdende måde for dit barn at udvikle deres fysiske og kognitive færdigheder på. Det er en fantastisk måde at holde dem beskæftiget og udfordre dem på samme tid. M

Fordele ved beskæringer: Hvorfor det er vigtigt at sørge for træpleje
Mange mennesker undervurderer vigtigheden af at beskære træer. Mens det kan virke irrelevant, så spiller træpleje faktisk en stor rolle i bevarelse af sikre og sunde omgivelser. For bygnings- eller gr

Gør en god handel på brugte høretelefoner
Markedet for high-end audio er vokset enormt de seneste år. Lydoplevelser er blevet en stor del af mange menneskers hverdag, og der er stadig flere, der ønsker at opgradere deres lydudstyr. Imidlertid

Udskiftning af kobling – Vi sikrer optimal kørsel af din bil
Når din bil begynder at have problemer med at skifte gear, eller accelerere, så kan det være tegn på, at koblingen trænger til udskiftning på et a utoværksted . En defekt kobling kan nemlig påvirke bi